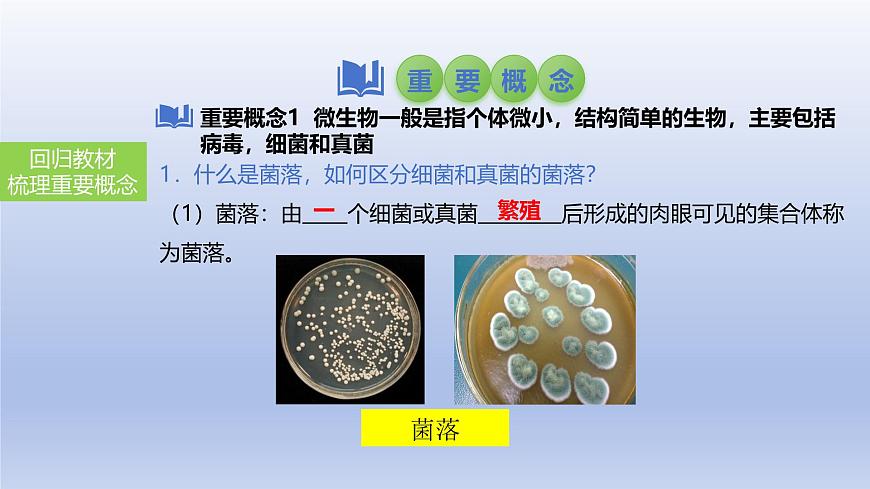
2025年初中生物会考一轮复习课件：第24讲 细菌、真菌和病毒的特征第3页

所属成套资源:2025年初中生物会考一轮复习课件
2025年初中生物会考一轮复习课件:第24讲 细菌、真菌和病毒的特征
展开
这是一份2025年初中生物会考一轮复习课件:第24讲 细菌、真菌和病毒的特征,共35页。PPT课件主要包含了培养基,高温灭菌,配制培养基,恒温培养,显微镜,巴斯德,巴氏消毒法,DNA,成形的细胞核,叶绿体等内容,欢迎下载使用。
1.什么是菌落,如何区分细菌和真菌的菌落?(1)菌落:由 个细菌或真菌 后形成的肉眼可见的集合体称为菌落。
1.什么是菌落,如何区分细菌和真菌的菌落?
(2)细菌和真菌菌落的区别:从菌落的形态、大小和颜色,可以大致区分细菌和真菌,以及它们的不同种类。①细菌的菌落:比较小,表面或 黏稠,或粗糙干燥。②真菌的菌落:一般比细菌菌落大几倍到几十倍,霉菌形成的菌落呈 状、絮状或蜘蛛网状,呈现红、褐、绿、黑、黄等不同的颜色。
2.培养细菌、真菌的一般方法是什么?(P67)
培养细菌、真菌的一般方法:配制 (内含营养物质)→ (杀死培养基上原有的细菌或真菌)→ (防止高温烫死接种的细菌或真菌)→ (在培养基上加入少量的细菌或真菌)→恒温培养(为细菌或真菌提供 的温度)。
培养细菌、真菌的一般方法
3.细菌和真菌生存需要什么基本条件?
细菌和真菌生存需要的基本条件:水、适宜的温度、有机物等。有的还要求某些特定的条件,如乳酸菌必须在无氧环境下生存。
1.细菌是如何被人们发现的?(P71-72)
(1)荷兰人列文虎克用自制的 发现了细菌的存在。(2)法国科学家 设计了一个鹅颈瓶实验(如图所示),证明了细菌不是自然发生的,而是由原来已经存在的细菌产生的。他还发现了乳酸菌、酵母菌,提出了保存酒和牛奶的 以及防止手术感染的方法,后人称他为“微生物学之父”。
2.细菌具有哪些形态结构特征?
(1)细菌的形态:细菌的个体十分微小,都是单细胞,只有用 显微镜或电镜才能观察到细菌的形态。根据细菌外部形态的不同,大致可以分为三类: 、杆菌、螺旋菌。
所有的细菌都是单细胞生物
(2)细菌的结构①细菌的基本结构(如图):细胞壁、细胞膜、细胞质、 。与动植物细胞的主要区别是,细菌虽然有DNA集中的区域,却没有 。这样的生物称为 生物。细菌没有 ,大多数细菌只能利用现成的有机物生活,并把有机物分解为水、无机盐和二氧化碳,它们是生态系统的分解者。
(2)细菌的结构②细菌的特殊结构(如图):有的细菌还有鞭毛、荚膜。 有助于细菌在液体环境中游动; 对细菌具有一定的保护作用,通常与细菌的致病性有关。
细菌与动植物细胞相比,最大的不同之处是:没有成形的细胞核
细菌与植物细胞相比,没有叶绿体,属于异养生物。
3.细菌是怎样进行生殖的?
(1)细菌的生殖方式: 生殖。也就是一个细菌分裂成两个细菌。(2)芽孢:有些细菌在生长发育后期,个体缩小, 增厚,形成芽孢。芽孢是细菌的 ,对不良环境有较强的抵抗能力。
1.生活中常见的真菌有哪些?
生活中常见的真菌有:多细胞真菌,如霉菌、蘑菇、银耳、木耳等;单细胞真菌,如酵母菌。
2.真菌细胞的结构具有什么特点?
(1)酵母菌细胞的结构(如图1):细胞壁、细胞膜、细胞质、 ;细胞质内有 。
(2)青霉的菌体结构(如图2):由许多细胞连起来的 构成的。每个细胞都有细胞壁、细胞膜、细胞质、细胞核。组成青霉的菌丝有两种:在营养物质表面向上生长的,叫 菌丝,在直立菌丝的顶端,长有成串(扫帚状)的青绿色的孢子;深入营养物质内部的,叫 菌丝。营养菌丝能从营养物质内吸收 ,供霉菌利用。
(3)蘑菇的菌体结构(如图):由许多细胞连起来的菌丝构成的。地下部分是菌丝,能够吸收水和 ;地上部分叫 ,由菌柄和菌盖组成。
综合酵母菌、青霉和蘑菇的特征,真菌的细胞都有细胞壁、细胞膜、细胞质、细胞核。与细菌的主要区别是,有 。这样的生物称为 生物。真菌没有 ,只能利用现成的有机物生活,并把有机物分解为水、无机盐和二氧化碳,它们是生态系统的 者。
3.真菌是怎样进行生殖的?
(1)酵母菌的生殖方式(如右图):酵母菌上长出一个突起,叫 ,这是酵母菌在进行 生殖。另外,酵母菌也可以进行孢子生殖。(2)霉菌、蘑菇的生殖方式: 生殖。
1.病毒的种类有哪些?(P90)
(1)病毒的大小:病毒很小,只能用纳米来表示它们的大小,要借助 显微镜才能看到。(2)病毒的种类:根据它们寄生的细胞不同,可以将病毒分为三大类,即动物病毒、植物病毒、细菌病毒(又叫 )。
2.病毒的结构有什么特点?
病毒的结构简单,由 外壳和内部的 组成,没有 结构。
3.病毒是怎样繁殖的?
病毒只能 在活细胞里,靠自己的遗传物质的 ,利用细胞内的物质,制造出新的病毒,这是它的 方式。新生成的病毒又可以感染其他活细胞。病毒要是离开了活细胞,通常会变成 。
4.病毒与人类的生活有什么关系?
(1)病毒对人类的危害:导致动植物和人患病,如新型冠状病毒引起的新冠病毒感染。(2)人类对病毒的利用:①经过人工处理的减毒的或无毒的病毒制成 ,预防病毒性疾病。②让某些病毒携带动植物或微生物的某些基因进入受体细胞,来达到转基因或基因治疗的目的。
典例1:下列关于菌落的叙述中,不正确的一项是( ) A.用肉眼能看见一大堆细菌或真菌就叫菌落B.菌落是由一个细菌或真菌繁殖后形成的C.细菌的菌落一般比真菌小D.只要有合适条件,不需要人工培养,在自然条件下也可以形成菌落
菌落:由一个细菌或真菌繁殖后形成的肉眼可见的集合体称为菌落。
变式1:某同学将装有培养基的培养皿直接暴露在空气中一段时间后进行培养,结果如图所示。下列有关叙述中,正确的是( )A.霉菌菌落通常比细菌菌落大,说明空气中霉菌数量更多B.培养基中的细菌和霉菌来自空气和培养皿C.该实验可以测定空气中微生物的种类D.一个细菌菌落中可能有几种细菌
典例2:金黄色葡萄球菌是一种常见的致病菌,食物被金黄色葡萄球菌污染,可能会造成食物中毒。金黄色葡萄球菌不具有的结构是( )A.细胞壁 组织膜 C.成形的细胞核 D.细胞质
细菌形态:球状、杆状、螺旋状细菌:无成形的细胞核,为原核生物
变式2:金色葡萄球菌是引起人患炎症的一类病菌,以下对金色葡萄球菌叙述中正确的是( )A.没有细胞壁 B. 组织内有叶绿体C.没有细胞结构 D.进行分裂生殖
典例3: 引起草莓灰霉病的病原生物有细胞壁、细胞核,能产生孢子,该病原生物属于( )A.草履虫 B.细菌 C.真菌 D.病毒
变式3:如图是青霉和蘑菇的结构示意图,下列叙述错误的是( ) A.都是多细胞真菌,菌体都由菌丝构成 B.孢子分别着生在结构①和b中C.结构③和d都主要吸收水和有机物 D.细胞内都有叶绿体,营养方式是自养
真菌没有叶绿体,只能利用现成的有机物生活
典例4: 病毒结构简单,没有细胞结构,由什么外壳和内部的遗传物质组成( )A.蛋白质 B.脂肪 C.维生素 D.葡萄糖
变式4:埃博拉病毒的出现,又一次引起人们对病毒的关注,下列说法正确的是( )A.所有病毒都会使人患病 B.病毒是靠分裂生殖的C.病毒是单细胞生物 D.病毒都是寄生的
相关课件
这是一份2025中考生物一轮复习课件 第24讲 细菌、真菌和病毒的特征课件,共35页。PPT课件主要包含了培养基,高温灭菌,配制培养基,恒温培养,显微镜,巴斯德,巴氏消毒法,DNA,成形的细胞核,叶绿体等内容,欢迎下载使用。
这是一份【2024年会考】初中生物 专题18 细菌、真菌和病毒-课件,共36页。PPT课件主要包含了内容要求,学习目标,考向一观察菌落,1配制培养基,2高温灭菌,3无菌接种,4恒温培养,真题再现,考向一细菌的发现,考向三细菌的生殖等内容,欢迎下载使用。
这是一份初中生物中考复习 八、(二)细菌、真菌和病毒课件PPT,共34页。PPT课件主要包含了考点聚焦,电镜或高倍显微镜,细胞质,DNA,细胞膜,细胞壁,独立生活,分裂生殖,名师点拨,归纳拓展等内容,欢迎下载使用。
相关课件 更多
- 1.电子资料成功下载后不支持退换,如发现资料有内容错误问题请联系客服,如若属实,我们会补偿您的损失
- 2.压缩包下载后请先用软件解压,再使用对应软件打开;软件版本较低时请及时更新
- 3.资料下载成功后可在60天以内免费重复下载

 免费领取教师福利
免费领取教师福利














